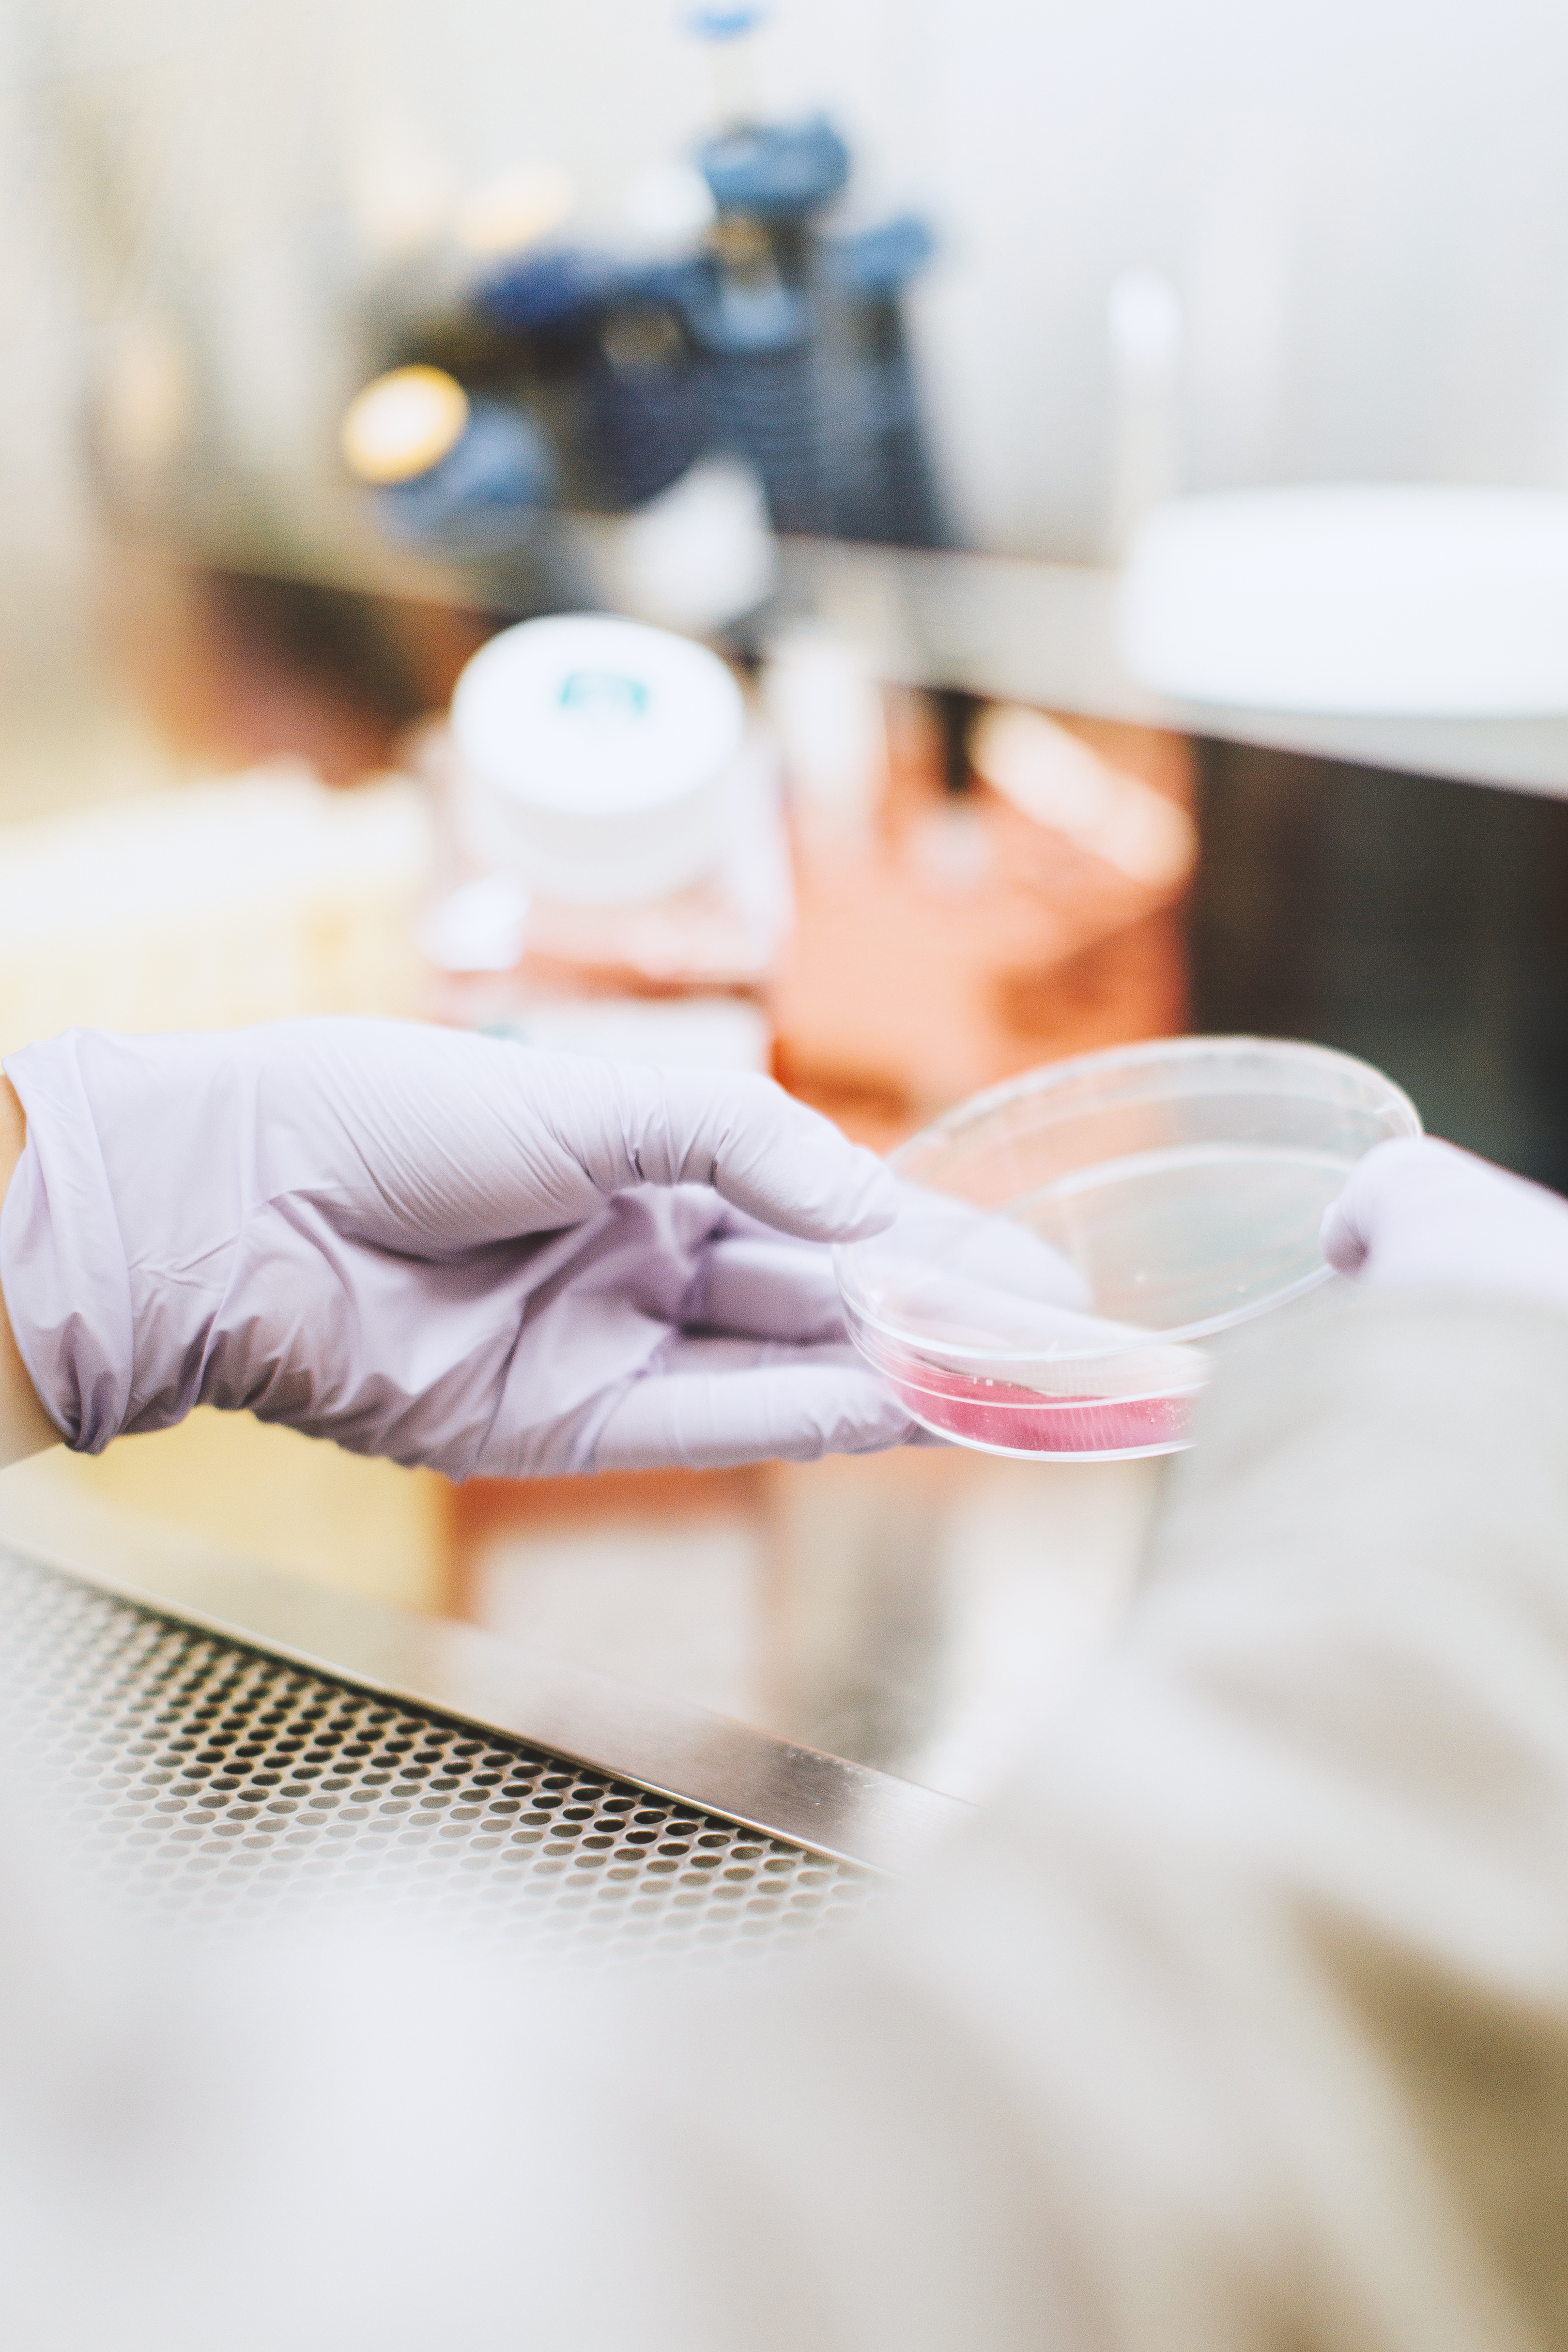

• Automatisierungstechnik
Wir denken, fokussieren und schaffen neue Produkte, welche Erfahrungen generieren, Verbindungen stärken und Standarts auflösen.
• Geräte
Wir denken, fokussieren und schaffen neue Produkte, welche Erfahrungen generieren, Verbindungen stärken und Standarts auflösen.
• Ersatzteile
Wir denken, fokussieren und schaffen neue Produkte, welche Erfahrungen generieren, Verbindungen stärken und Standarts auflösen.
• Reparatur
Wir denken, fokussieren und schaffen neue Produkte, welche Erfahrungen generieren, Verbindungen stärken und Standarts auflösen.
• Systemtechnik
Wir denken, fokussieren und schaffen neue Produkte, welche Erfahrungen generieren, Verbindungen stärken und Standarts auflösen.
• Konzeption
Wir denken, fokussieren und schaffen neue Produkte, welche Erfahrungen generieren, Verbindungen stärken und Standarts auflösen.
• Vermittlung
Wir denken, fokussieren und schaffen neue Produkte, welche Erfahrungen generieren, Verbindungen stärken und Standarts auflösen.
• Installation
Wir denken, fokussieren und schaffen neue Produkte, welche Erfahrungen generieren, Verbindungen stärken und Standarts auflösen.
• Schulungen
Wir denken, fokussieren und schaffen neue Produkte, welche Erfahrungen generieren, Verbindungen stärken und Standarts auflösen.